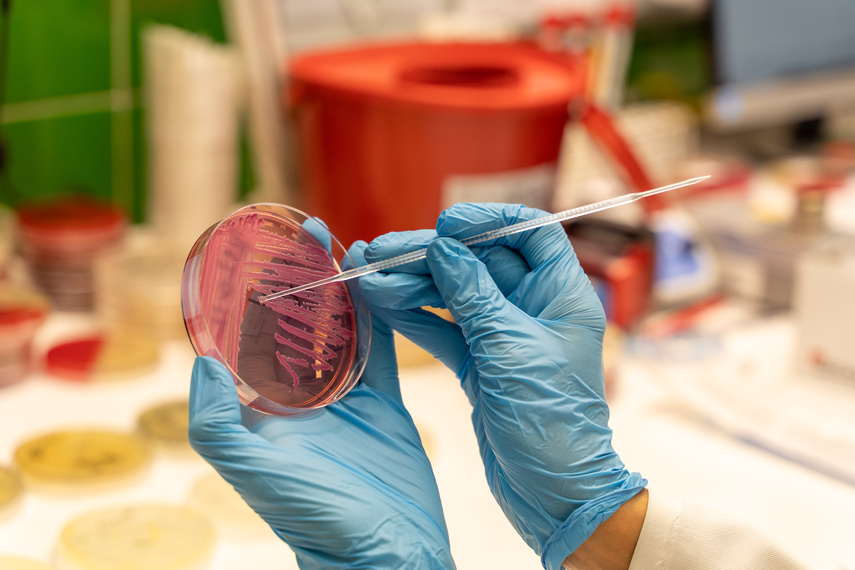
“Antybiotykoterapia musi być precyzyjna” zdjęcie nr 273306
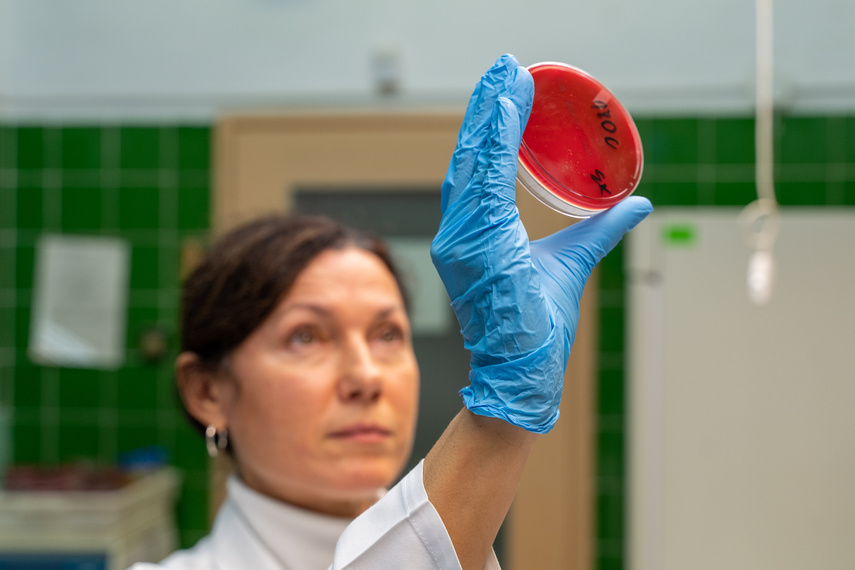
“Antybiotykoterapia musi być precyzyjna” zdjęcie nr 273310
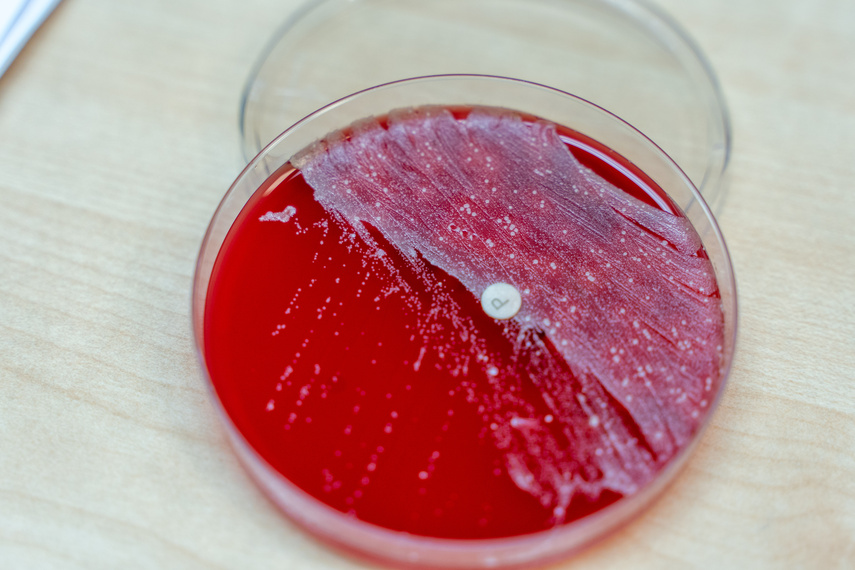
“Antybiotykoterapia musi być precyzyjna” zdjęcie nr 273317

----
(2022-11-18)Fot. Mikołaj Sobczak“Antybiotykoterapia musi być precyzyjna”
Wojewódzki Szpital Zespolony w swoich strukturach ma Laboratorium Bakteriologiczne, co umożliwia placówce między innymi szybkie i precyzyjne zapewnienie terapii antybiotykowej pacjentom. Między innymi o tym, jak ważna jest tzw. ochrona antybiotyków w ochronie zdrowia pacjentów, opowiada Halina Serafin, kierownik laboratorium.
Przeczytaj więcej w artykule związanym z tym fotoreportażem.
Przeczytaj więcej w artykule związanym z tym fotoreportażem.